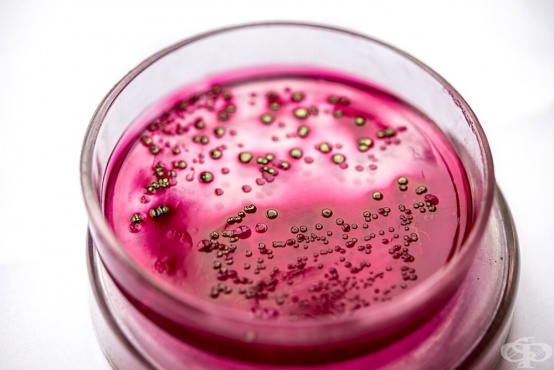

- Какво представлява дизентерията?
- Епидемиология на дизентерията
- Видове дизентерия
- Начин на заразяване с дизентерия
- Причинител на дизентерия
- Рискови фактори за дизентерия
- Симптоми на дизентерия
- Усложнения при дизентерия
- Кога да се консултирате с лекар при симптоми на дизентерия?
- Изследвания при дизентерия
- Диференциална диагноза на дизентерия
- Лечение на дизентерия
- Хранене при дизентерия
- Прогноза при дизентерия
- Как да се предпазим от дизентерия?
- Дизентерия при деца
15. Как да се предпазим от дизентерия?

Най-добрият начин за предотвратяване на дизентерия е спазването на добра хигиена.
Епидемиите на дизентерия обикновено възникват в резултат на лоша хигиена или санитарни условия. За да се намали рискът от инфекция, хората трябва да мият ръцете си редовно със сапун и вода, особено след използване на тоалетната и преди приготвяне на храна.
Рискът от заразяване с дизентерия е по-висок за хората, пътуващи до страни с топъл, влажен климат и лоши санитарни условия. Когато пътува до такива места, човек трябва да:
- пиене на вода само от надежден източник, като бутилирана вода
- консумация на бутилираната вода с ненарушено уплътнение преди първото й отваряне
- избягване на кубчета лед, тъй като водата може да е от замърсен източник
- употреба само бутилирана или пречистена вода за миене на зъбите
- избягване на консумация на непастьоризирано мляко или млечни продукти
- старателно и добре готвене на храната старателно преди ядене (да не остане сурова)
За да се предотврати предаването на дизентерия от човек на човек при диагностициране с инфекцията, трябва да се прилагат следните предпазни мерки:
- често измиване на ръцете, особено след използване на банята и преди готвене
- избягване на всякакъв секс, включително орален, вагинален и анален, докато диарията спре за поне една седмица
- избягване на плуването, докато диарията не отшуми поне една седмица
Следва: Дизентерия при деца
googletag.pubads().definePassback('/21812339056/300-250-upperright', [300, 250]).display();

Коментари към Дизентерия